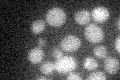
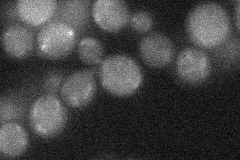
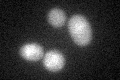

View description
Negative regulatory subunit of protein phosphatase 1 Ppz1p and also a subunit of the phosphopantothenoylcysteine decarboxylase (PPCDC; Cab3p, Sis2p, Vhs3p) complex, which catalyzes the third step of coenzyme A biosynthesis
Localization:
Intensity:
Fold change:
Significance:
-
C’ GFP library in SD
below threshold16.87 -
N' NOP1pr-GFP in SD

cytosol59.7855 -
N' TEF2pr-mCherry in SD

cell periphery,vacuole0 -
N' NATIVEpr-GFP in SD
punctate20.936 -
N' TEF2pr-VC and Cyto-VN in SD

#N/A0 -
C’ GFP library in SD+DTT
cytosol16.931No -
C’ GFP library in SD+H2O2

cytosol19.321.14No -
C’ GFP library in Starvation Media

cytosol15.260.9No -
C’ GFP library on the background of Pup2-DaMP

below threshold -
C’ GFP library on the background of CCT mutant

below threshold17.21221.01951No
